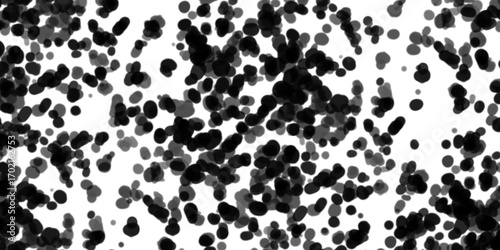

Download sample
File Details
Published: 2025-09-13 15:18:08.770996 Category: Graphic Resources Type: Illustration Model release: NoShare
Isolated fluffy dark bubble isolated on transparent background
Contributor: ABIRR GD7
ID : 1702162753
